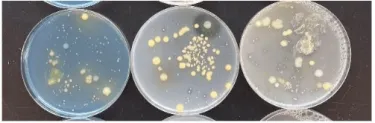

In the spring of 2025 UVM Extension Northwest Crops and Soils Program (NWCS) sent a call out to organic dry bean growers in the Northeastern U.S. to send in seed samples for evaluation of seed health and seedborne pathogens. Growers in the Northeast have indicated sourcing quality seed and a lack in pest management practices are significant barriers to dry bean production in the region. This project was designed to start addressing these concerns and identify what seedborne pathogens exist in the seed lots across the Northeast.
The majority of dry bean production in this region is certified organic, with many farmers choosing to save their own seed. This decision is driven in part by the lack of seed sources for heirloom and specialty dry bean varieties that consumers prefer. It is critical for dry bean growers to plant disease-free seed as other disease management options are often limited in organic production systems. Planting clean seed reduces the risk of a disease outbreak during the season that could decrease yields. As growers continue to save their seed for planting from year-to-year the risk of seedborne pathogen build up can increase (Image 1).
The UVM NWCS Team and the UVM Plant Diagnostic Clinic (PDC) teamed up to find out what major seedborne pathogens are targeting organic dry bean production in this region. This survey will lay the foreground for further research into dry bean disease management practices. In this survey, the team received 25 samples from ME, NY, and VT. Over 50% of the samples submitted were from saved seed lots. These samples represented 8 different market classes and 17 different varieties.
The PDC used modified ISTA methods to identify nine different fungal pathogens including Alternaria, Cercospora, Ascochyta, Fusarium, Macrophomina, Rhizoctonia, Sclerotinia, Tricothecium, and Colletotrichum (Image 2). As well as bacterial pathogens including Pseudomonas savastanoi pv. phaseolicola, P. syringae pv. syringae (halo blight), Xanthomonas citri pv. fuscans (Xcf), and X. phaseoli pv. phaseoli (Xpp, common bean blight) (Image 3). Secondary molds including yeasts, Cladosporium, Penicillium, Rhizopus, and Aspergillus, were also evaluated in this survey. The results from the 2025 Seedborne Pathogen Survey Summarized Report can be found here.
Seed Health Results
Germination was assessed using 200 seeds per sample. The germination ranged from 0 to 98% among the 25 samples with an average germination of 66%. The seed vigor test evaluated 100 seeds per sample, measuring the total growth from the seed in centimeters after a 7-day incubation period. Having a higher seed vigor index value indicates quicker development and emergence leading to a more uniform stand. The Seed Vigor Index ranged from 0 to 528 among the 25 samples submitted with an average Seed Vigor Index of 166.
Each sample submitted had fungal or bacterial pathogens observed in the seed lots. The most common diseases present in this survey were common bacterial blight (80%) and halo blight (60%). Although fungal pathogens were not observed in high numbers compared to the bacterial pathogens, they can still pose a threat. Fields should be regularly scouted to monitor the various diseases associated with these pathogens. The PDC and NWCS team put together the Growers Guide to Seedborne Diseases of Dry Beans to provide growers guidance for identifying these diseases in the field and what the current management strategies are out there.
For more information regarding dry beans please visit the NWCS website. The summarized report for this survey can be found on both the NWCS website or the Northern Grain Growers Collaborative website.